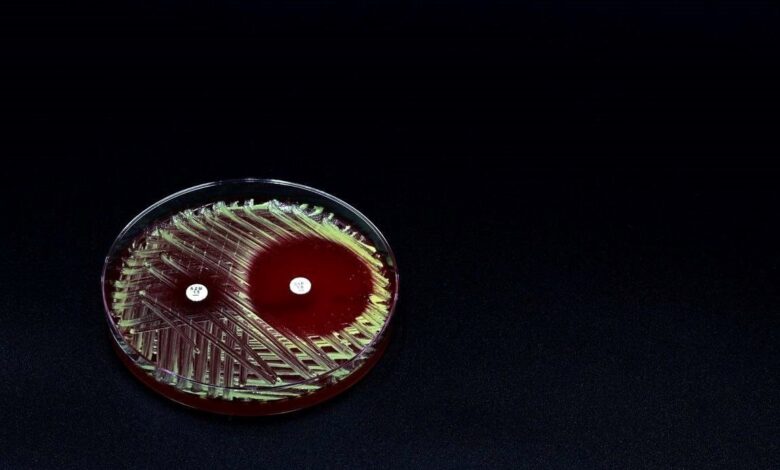

نانوژلهای ضدباکتری: راهی برای مقابله با عفونتهای مقاوم
پژوهشگران نانوژِلهایی ساختند که میتوانند در برابر باکتریهای مقاوم به آنتیبیوتیکها بسیار موثر عمل کنند. این نانوژِلها ترکیبی از قندها و پپتیدهای خاص دارند که به باکتریها متصل شده و باعث تخریب غشای آنها میشوند.
به گزارش سیناپرس، آزمایشها نشان دادهاند که میتوانند بیش از ۹۹ درصد باکتریها را از بین ببرند و حتی در برابر بیوفیلمهای مقاوم به درمانهای معمولی نیز موثر باشند.
این فناوری علاوه بر عملکرد ضدباکتریایی بالا، از نظر زیستی بیخطر بوده و به سلولهای سالم آسیب نمیزند. محققان پیشبینی میکنند که این دستاورد میتواند در آینده به درمانهای نوین برای عفونتهای بیمارستانی و بیماریهای ناشی از باکتریهای مقاوم تبدیل شود.





